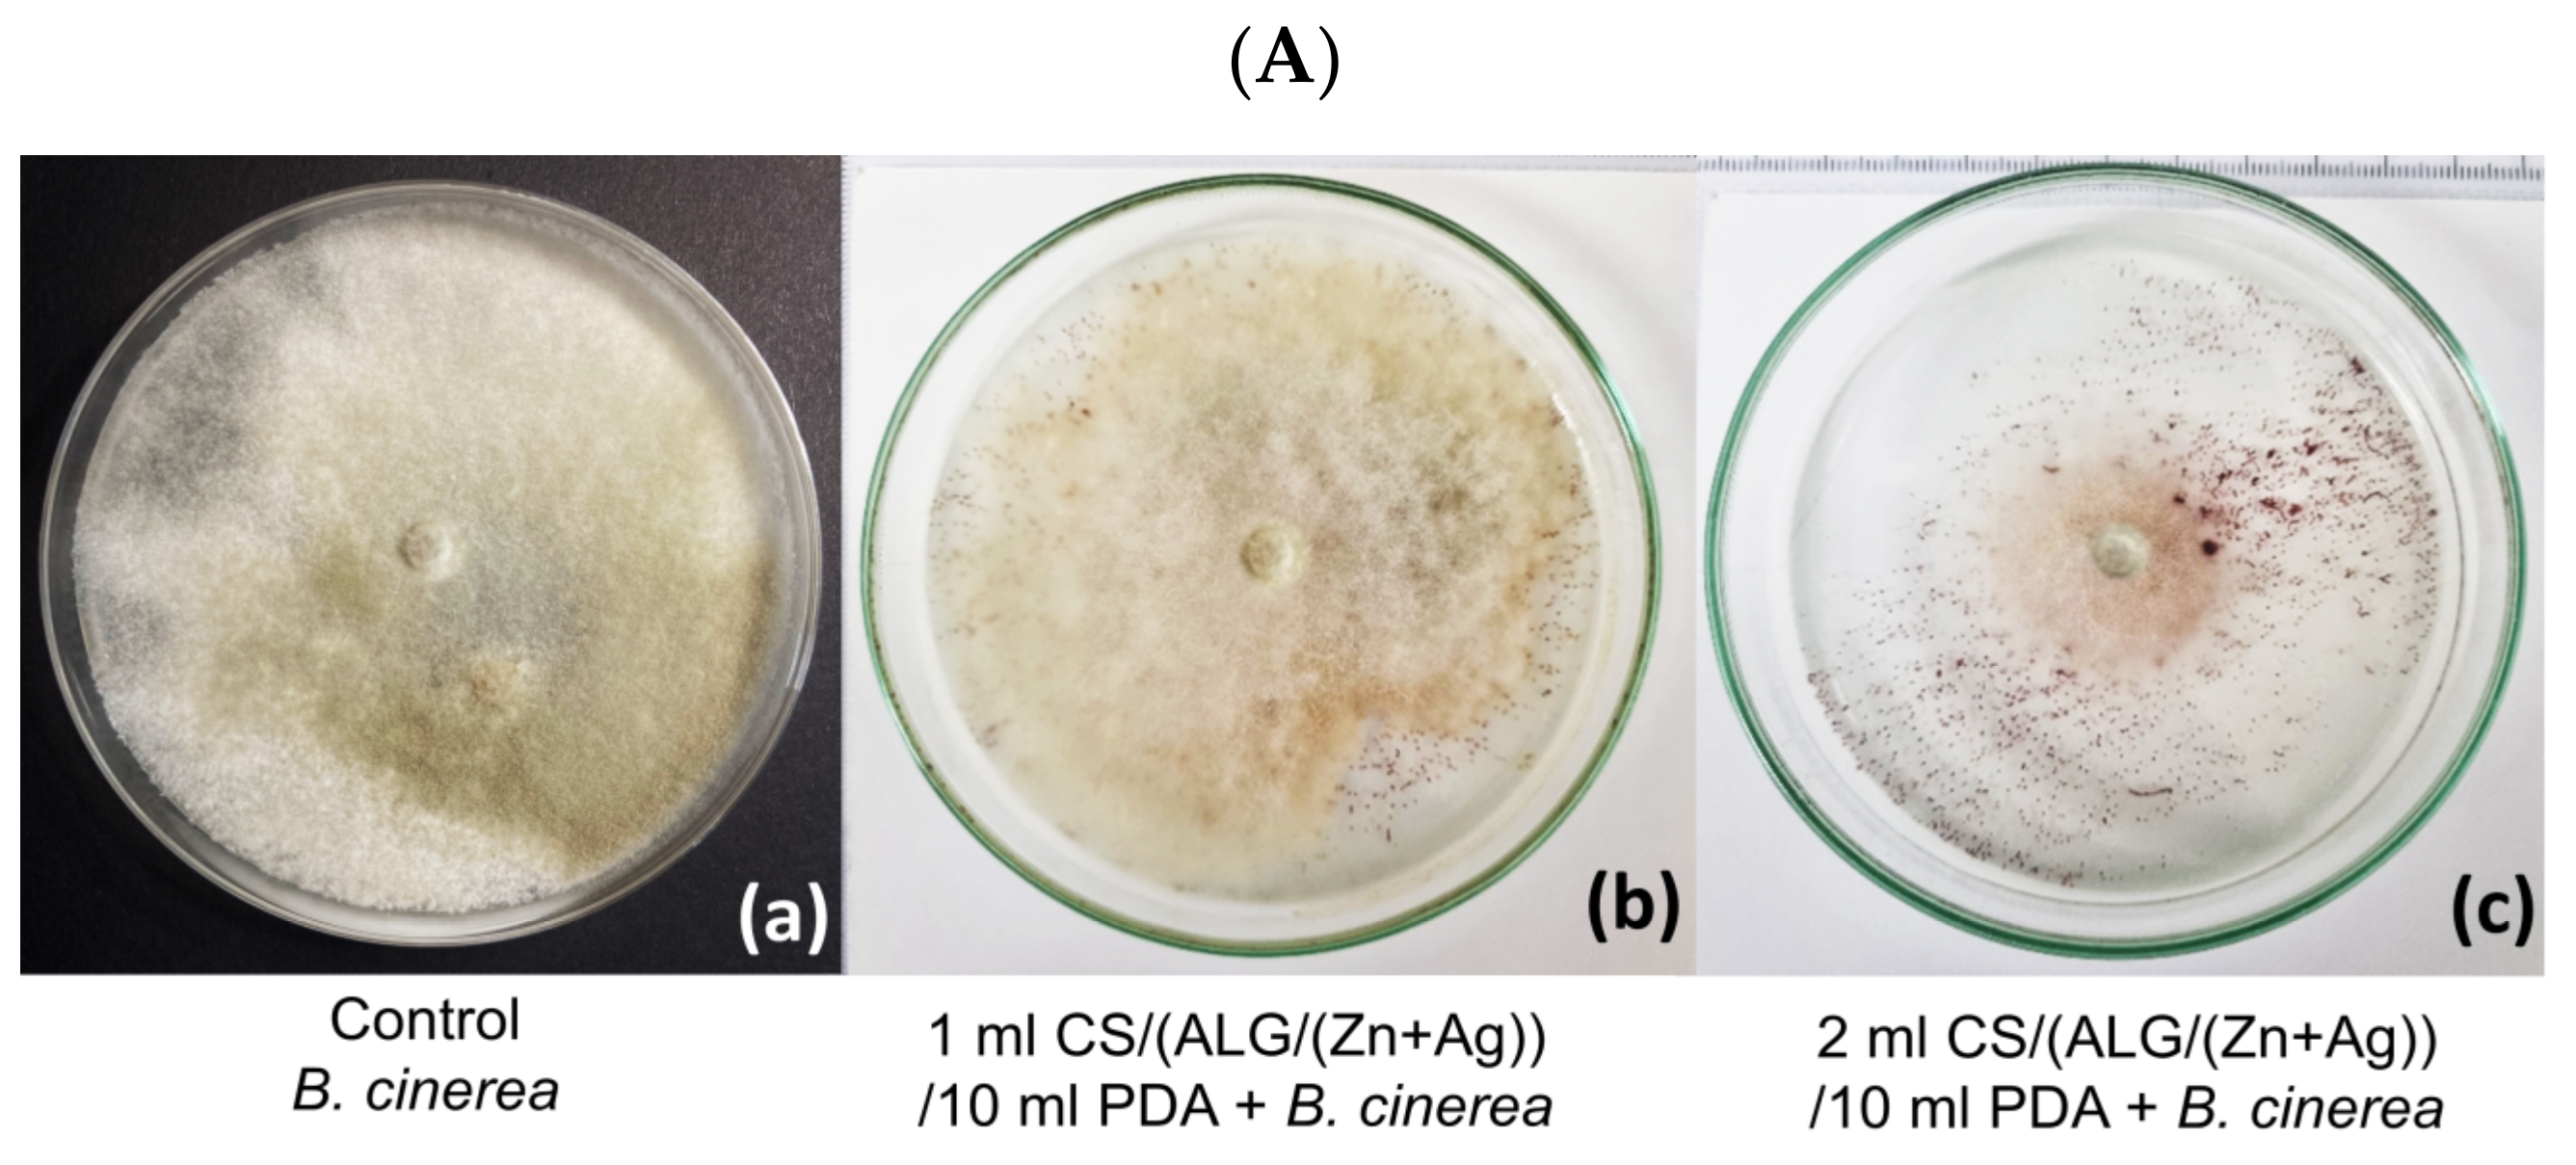
Polymers 15 04359 g007a

Novel Zinc/Silver Ions-Loaded Alginate/Chitosan Microparticles Antifungal Activity against Botrytis cinerea
Abstract
:1. Introduction
2. Materials and Methods
2.1. Materials
2.1.1. Microparticle Preparation
2.1.2. Test Organism
2.2. Methods
2.2.1. Chemical Fingerprinting by Fourier Transform Infrared Spectroscopy Coupled with Attenuated Total Reflectance (ATR)
2.2.2. Microscopic Observations
- (a)
- Microscopic analysis of microparticle size, surface morphology, and topography
- (b)
- Microscopic analysis of the potential antifungal effect on the microstructures of B. cinerea
2.2.3. Encapsulation Efficiency and Loading Capacity
- (a)
- Encapsulation efficiency (EE)
- (b)
- Loading capacity (LC)
2.2.4. Swelling Degree (Sw)
2.2.5. In Vitro Active Agents Release
2.2.6. Testing the Antifungal Effect of Microparticles on the Growth of B. Cinerea
2.2.7. Statistical Analysis
3. Results and Discussion
3.1. Evaluation of Microparticle Physicochemical Properties
3.1.1. Identification of Interactions between Microparticle Constituents
3.1.2. Size, Surface Morphology, and Topography of Microparticles
3.1.3. Encapsulation Efficiency, Loading Capacity, Swelling Degree, and Cation Releasing from Microparticles
3.2. Antifungal Effect of Microparticles on the B. cinerea Growth
4. Conclusions
Author Contributions
Funding
Institutional Review Board Statement
Data Availability Statement
Conflicts of Interest
References
- Özkara, A.; Akyil, D.; Konuk, M. Pesticides, Environmental Pollution, and Health. In Environmental Health Risk—Hazardous Factors to Living Species; IntechOpen: London, UK, 2016; Chapter 1; pp. 1–27. [Google Scholar] [CrossRef]
- Kumari, D.; John, S. Safety and Occupational Health Hazards of Agricultural Workers Handling Pesticides: A Case Study. In Advances in Health and Environment Safety; Springer Transactions in Civil and Environmental Engineering; Springer: Singapore, 2018; pp. 75–82. [Google Scholar] [CrossRef]
- Mahesha, H.S.; Vinay, J.U.; Ravikumar, M.R.; Visweswarashastry, S.; Keerthi, M.C.; Halli, H.M.; Shokralla, S.; El-Abedin, T.K.Z.; Mahmoud, E.A.; Elansary, H.O. Colloidal Silver Hydrogen Peroxide: New Generation Molecule for Management of Phytopathogens. Horticulturae 2021, 7, 573. [Google Scholar] [CrossRef]
- Prasad, R. Synthesis of silver nanoparticles in photosynthetic plants. J. Nanopart. 2014, 2014, 963961. [Google Scholar] [CrossRef]
- Anand, R.; Bhagat, M. Silver nanoparticles (AgNPs): As nanopesticides and nanofertilizers. MOJ Biol. Med. 2019, 4, 18–20. [Google Scholar] [CrossRef]
- Gupta, N.; Upadhyaya, C.P.; Singh, A.; Abd-Elsalam, K.A.; Prasad, R. Applications of Silver Nanoparticles in Plant Protection. In Nanobiotechnology Applications in Plant Protection; Nanotechnology in the Life Sciences; Springer: Cham, Switzerland, 2018; pp. 247–265. [Google Scholar] [CrossRef]
- Cabot, C.; Martos, S.; Llugany, M.; Gallego, B.; Tolrà, R.; Poschenrieder, C. A Role for Zinc in Plant Defense Against Pathogens and Herbivores. Front. Plant Sci. 2010, 10, 1171. [Google Scholar] [CrossRef]
- Montalvo, D.; Degryse, F.; da Silva, R.C.; Baird, R.; McLaughlin, M.J. Agronomic Effectiveness of Zinc Sources as Micronutrient Fertilizer. Adv. Agron. 2016, 139, 215–267. [Google Scholar] [CrossRef]
- Kaur, H.; Garg, N. Zinc toxicity in plants: A review. Planta 2021, 253, 129. [Google Scholar] [CrossRef] [PubMed]
- Yan, A.; Chen, Z. Impacts of Silver Nanoparticles on Plants: A Focus on the Phytotoxicity and Underlying Mechanism. Int. J. Mol. Sci. 2019, 20, 1003. [Google Scholar] [CrossRef] [PubMed]
- Vinceković, M.; Jalšenjak, N.; Topolovec-Pintarić, S.; Đermić, E.; Bujan, M.; Jurić, S. Encapsulation of Biological and Chemical Agents for Plant Nutrition and Protection: Chitosan/Alginate Microcapsules Loaded with Copper Cations and Trichoderma viride. J. Agric. Food Chem. 2016, 64, 8073–8083. [Google Scholar] [CrossRef] [PubMed]
- Riseh, R.S.; Hassanisaadi, M.; Vatankhah, M.; Soroush, F.; Varma, R.S. Nano/microencapsulation of plant biocontrol agents by chitosan, alginate, and other important biopolymers as a novel strategy for alleviating plant biotic stresses. Int. J. Biol. Macromol. 2022, 222, 1589–1604. [Google Scholar] [CrossRef] [PubMed]
- Jurić, S.; Jurić, M.; Režek Jambrak, A.; Vinceković, M. Tailoring Alginate/Chitosan Microparticles Loaded with Chemical and Biological Agents for Agricultural Application and Production of Value-Added Foods. Appl. Sci. 2021, 11, 4061. [Google Scholar] [CrossRef]
- Riseh, R.S.; Hassanisaadi, M.; Vatankhah, M.; Babaki, S.A.; Barka, E.A. Chitosan as a potential natural compound to manage plant diseases. Int. J. Biol. Macromol. 2022, 220, 998–1009. [Google Scholar] [CrossRef] [PubMed]
- Riseh, R.S.; Vatankhah, M.; Hassanisaadi, M.; Kennedy, J.F. Chitosan/silica: A hybrid formulation to mitigate phytopathogens. Int. J. Biol. Macromol. 2023, 239, 124192. [Google Scholar] [CrossRef]
- Krasaekoopt, W.; Bhandari, B.; Deeth, H. Evaluation of encapsulation techniques of probiotics for yoghurt. Int. Dairy J. 2003, 13, 3–13. [Google Scholar] [CrossRef]
- Lucinda-Silva, R.M.; Salgado, H.R.N.; Evangelista, R.C. Alginate–chitosan systems: In vitro controlled release of triamcinolone and in vivo gastrointestinal transit. Carbohydr. Polym. 2010, 81, 260–268. [Google Scholar] [CrossRef]
- Li, L.; Wang, L.; Li, J.; Jiang, S.; Wang, Y.; Zhang, X.; Ding, J.; Yu, T.; Mao, S. Insights into the mechanisms of chitosan–anionic polymers-based matrix tablets for extended drug release. Int. J. Pharm. 2014, 476, 253–265. [Google Scholar] [CrossRef]
- Cheung, N.; Tian, L.; Liu, X.; Li, X. The Destructive Fungal Pathogen Botrytis cinerea—Insights from Genes Studied with Mutant Analysis. Pathogens 2020, 9, 923. [Google Scholar] [CrossRef]
- Guzmán, C.; Bagga, M.; Kaur, A.; Westermarck, J.; Abankwa, D. ColonyArea: An ImageJ Plugin to Automatically Quantify Colony Formation in Clonogenic Assays. PLoS ONE 2014, 9, e92444. [Google Scholar] [CrossRef] [PubMed]
- Xue, W.M.; Yu, W.T.; Liu, X.D.; He, X.; Wang, W.X.; Ma, J. Chemical method of breaking the cell-loaded sodium alginate/chitosan microcapsules. Chem. J. Chin. Univ. 2004, 25, 1342–1346. Available online: http://www.cjcu.jlu.edu.cn/EN/Y2004/V25/I7/1342 (accessed on 9 October 2023).
- Li, X.Y.; Jin, L.J.; McAllister, T.A.; Stanford, K.; Xu, J.Y.; Lu, Y.N.; Zhen, Y.H.; Sun, Y.X.; Xu, Y.P. Chitosan-alginate microcapsules for oral delivery of egg yolk immunoglobulin (IgY). J. Agric. Food Chem. 2007, 55, 2911–2918. [Google Scholar] [CrossRef] [PubMed]
- Mokale, V.; Jitendra, N.; Yogesh, S.; Gokul, K. Chitosan reinforced alginate controlled release beads of losartan potassium: Design, formulation and in vitro evaluation. J. Pharm. Investig. 2014, 44, 243–252. [Google Scholar] [CrossRef]
- Fraternale, D.; Giamperi, L.; Ricci, D. Chemical Composition and Antifungal Activity of Essential Oil Obtained from In Vitro Plants of Thymus mastichina L. J. Essent. Oil Res. 2003, 15, 278–281. [Google Scholar] [CrossRef]
- Sartori, C.; Finch, D.S.; Ralph, B. Determination of the cation content of alginate thin films by FT IR Spectroscopy. Polymer 1997, 38, 43–51. [Google Scholar] [CrossRef]
- Sankalia, M.G.; Mashru, R.C.; Sankalia, J.M.; Sutariya, V.B. Reversed chitosan-alginate polyelectrolyte complex for stability improvement of alpha-amylase: Optimization and physicochemical characterization. Eur. J. Pharm. Biopharm. 2007, 65, 215–232. [Google Scholar] [CrossRef] [PubMed]
- Lawrie, G.; Keen, I.; Drew, B.; Chandler-Temple, A.; Rintoul, L.; Fredericks, P.; Grøndahl, L. Interactions between alginate and chitosan biopolymers characterized using FTIR and XPS. Biomacromolecules 2007, 6, 2533–2541. [Google Scholar] [CrossRef]
- Upadhyay, P.; Mishra, S.K.; Purohit, S.; Dubey, G.P.; Singh Chauhan, B.; Srikrishna, S. Antioxidant, antimicrobial and cytotoxic potential of silver nanoparticles synthesized using flavonoid rich alcoholic leaves extract of Reinwardtia indica. Drug Chem. Toxicol. 2018, 42, 65–75. [Google Scholar] [CrossRef] [PubMed]
- Saha, J.; Podder, J. Crystallization Of Zinc Sulphate Single Crystals and Its Structural, Thermal and Optical Characterization. J. Bangladesh Acad. Sci. 2012, 35, 203–210. [Google Scholar] [CrossRef]
- Straccia, M.C.; d’Ayala, G.G.; Romano, I.; Laurienzo, P. Novel zinc alginate hydrogels prepared by internal setting method with intrinsic antibacterial activity. Carbohydr. Polym. 2015, 125, 103–112. [Google Scholar] [CrossRef] [PubMed]
- Agulhon, P.; Markova, V.; Robitzer, M.; Quignard, F.; Mineva, T. Structure of Alginate Gels: Interaction of Diuronate Units with Divalent Cations from Density Functional Calculations. Biomacromolecules 2012, 13, 1899–1907. [Google Scholar] [CrossRef] [PubMed]
- Taha, O.M.; Nasser, W.; Ardakani, A.; Alkhatib, H.S. Sodium lauryl sulfate impedes drug release from zinc-crosslinked alginate beads: Switching from enteric coating release into biphasic profiles. Int. J. Pharm. 2008, 350, 291–300. [Google Scholar] [CrossRef]
- Campañone, L.; Bruno, E.; Martino, M. Effect of microwave treatment on metal-alginate beads. J. Food Eng. 2014, 135, 26–30. [Google Scholar] [CrossRef]
- Gan, Y.; Bai, S.; Hu, S.; Zhao, X.; Li, Y. Reaction mechanism of thermally-induced electric conduction of poly(vinyl alcohol)–silver nitrate hybrid films. RSC Adv. 2016, 6, 56728–56737. [Google Scholar] [CrossRef]
- Lin, S.; Huang, R.; Cheng, Y.; Liu, J.; Lau, B.L.; Wiesner, M.R. Silver nanoparticle-alginate composite beads for point-of-use drinking water disinfection. Water Res. 2013, 47, 3959–3965. [Google Scholar] [CrossRef]
- Zhang, Y.; Yang, Y.; Zhao, X.; Gao, J. Investigation on ionic crosslinking of alginate by monovalent cations to fabricate alginate gel for biomedical application. React. Funct. Polym. 2023, 183, 105484. [Google Scholar] [CrossRef]
- Li, L.H.; Deng, J.C.; Deng, H.R.; Liu, Z.L.; Xin, L. Synthesis and characterization of chitosan/ZnO nanoparticles composite membranes. Carbohydr. Res. 2010, 345, 994–998. [Google Scholar] [CrossRef]
- Anandhavelu, S.; Thambidurai, S. Preparation of chitosan–zinc oxide complex during chitin deacetylation. Carbohydr. Polym. 2011, 83, 1565–1569. [Google Scholar] [CrossRef]
- Trzaskowski, B.; Adamowicz, L.; Deymier, P.A. A theoretical study of zinc(II) interactions with amino acid models and peptide fragments. JBIC J. Biol. Inorg. Chem. 2007, 13, 133–137. [Google Scholar] [CrossRef]
- AbdElhady, M.M. Preparation and Characterization of Chitosan/Zinc Oxide Nanoparticles for Imparting Antimicrobial and UV Protection to Cotton Fabric. Int. J. Carbohydr. Chem. 2012, 2012, 840591. [Google Scholar] [CrossRef]
- Wei, D.; Sun, W.; Qian, W.; Ye, Y.; Ma, X. The synthesis of chitosan-based silver nanoparticles and their antibacterial activity. Carbohydr Res. 2009, 344, 2375–2382. [Google Scholar] [CrossRef] [PubMed]
- Blandino, A.; Macías, M.; Cantero, D. Formation of calcium alginate gel capsules: Influence of sodium alginate and CaCl2 concentration on gelation kinetics. J Biosci. Bioeng. 1999, 88, 686–689. [Google Scholar] [CrossRef] [PubMed]
- Jurić, S.; Šegota, S.; Vinceković, M. Influence of surface morphology and structure of alginate microparticles on the bioactive agents release behavior. Carbohydr. Polym. 2019, 218, 234–242. [Google Scholar] [CrossRef] [PubMed]
- Klein, J.; Stock, J.; Vorlop, K.D. Pore size and properties of spherical Ca-alginate biocatalysts. Eur. J. Appl. Microbiol. Biotechnol. 1983, 18, 86–91. [Google Scholar] [CrossRef]
- Simpliciano, C.; Clark, L.; Asi, B.; Chu, N.; Mercado, M.; Diaz, S.; Goedert, M.; Mobed-Miremadi, M. Cross-Linked Alginate Film Pore Size Determination Using Atomic Force Microscopy and Validation Using Diffusivity Determinations. J. Surf. Eng. Mater. Adv. Technol. 2013, 3, 1–12. [Google Scholar] [CrossRef]
- Siepmann, J.; Siepmann, F. Modeling of diffusion controlled drug delivery. J. Control. Release 2012, 161, 351–362. [Google Scholar] [CrossRef]
- Roger, S.; Talbot, D.; Bee, A. Preparation and effect of Ca2+ on water solubility, particle release and swelling properties of magnetic alginate films. J. Magn. Magn. Mater. 2006, 305, 221–227. [Google Scholar] [CrossRef]
- Silva, R.M.; Silva, G.A.; Coutinho, O.P.; Mano, J.F.; Reis, J.L. Preparation and characterisation in simulated body conditions of glutaraldehyde crosslinked chitosan membranes. J. Mater. Sci. Mater. Med. 2004, 15, 1105–1112. [Google Scholar] [CrossRef]
- Bhattarai, N.; Gunn, J.; Zhang, M. Chitosan-based hydrogels for controlled, localized drug delivery. Adv. Drug Deliv. Rev. 2010, 31, 83–99. [Google Scholar] [CrossRef] [PubMed]
- Korsmeyer, R.W.; Gurny, R.; Doelker, E.; Buri, P.; Peppas, N.A. Mechanisms of solute release from porous hydrophilic polymers. Int. J. Pharm. 1983, 15, 25–35. [Google Scholar] [CrossRef]
- Guibal, E. Interactions of metal ions with chitosan-based sorbents: A review. Sep. Purif. Technol. 2004, 38, 43–74. [Google Scholar] [CrossRef]
- Shih, P.-Y.; Liao, Y.-T.; Tseng, Y.-K.; Deng, F.-S.; Lin, C.H. A Potential Antifungal Effect of Chitosan Against Candida albicans Is Mediated via the Inhibition of SAGA Complex Component Expression and the Subsequent Alteration of Cell Surface Integrity. Front. Microbiol. 2019, 10, 602. [Google Scholar] [CrossRef]
- Sharma, N.; Sharma, S. Control of foliar diseases of mustard by Bacillus from reclaimed soil. Microbiol. Res. 2008, 163, 408–413. [Google Scholar] [CrossRef]
- Yen, T.B.; Chang, H.T.; Hsieh, C.C.; Chang, S.T. Antifungal properties of ethanolic extract and its active compounds from Calocedrus macrolepis var. formosana (Florin) heartwood. Bioresour. Technol. 2008, 99, 4871–4877. [Google Scholar] [CrossRef] [PubMed]
- He, L.; Liu, Y.; Mustapha, A.; Lin, M. Antifungal activity of zinc oxide nanoparticles against Botrytis cinerea and Penicillium expansum. Microbiol. Res. 2011, 166, 207–215. [Google Scholar] [CrossRef] [PubMed]
- Sawai, J.; Yoshikawa, T. Quantitative evaluation of antifungal activity of metallic oxide powders (MgO, CaO and ZnO) by an indirect conductimetric assay. J. Appl. Microbiol. 2004, 96, 803–809. [Google Scholar] [CrossRef] [PubMed]
- Brayner, R.; Ferrari-Iliou, R.; Brivois, N.; Djediat, S.; Benedetti, M.F.; Fiévet, F. Toxicological impact studies based on Escherichia coli bacteria in ultrafine ZnO nanoparticles colloidal medium. Nano Lett. 2006, 6, 866–870. [Google Scholar] [CrossRef] [PubMed]
- Amro, N.A.; Kotra, L.P.; Wadu-Mesthrige, K.; Bulychev, A.; Mobashery, S.; Liu, G. High-resolution atomic force microscopy studies of the Escherichia coli outer membrane: Structural basis for permeability. Langmuir 2000, 16, 2789–2796. [Google Scholar] [CrossRef]
- Alvarez-Peral, F.J.; Zaragoza, O.; Pedreno, Y.; Arguelles, J.C. Protective role of trehalose during severe oxidative stress caused by hydrogen peroxide and the adaptive oxidative stress response in Candida albicans. Microbiology 2002, 148, 2599–2606. [Google Scholar] [CrossRef] [PubMed]
- Kim, K.J.; Sung, W.S.; Moon, S.K.; Choi, J.S.; Kim, J.G.; Lee, D.G. Antifungal effect of silver nanoparticles on dermatophytes. J. Microbiol. Biotechnol. 2008, 18, 1482–1484. [Google Scholar]
- Kim, K.J.; Sung, W.S.; Suh, B.K.; Moon, S.K.; Choi, J.S.; Kim, J.G.; Lee, D.G. Antifungal activity and mode of action of silver nano-particles on Candida albicans. Biometals 2009, 22, 235–242. [Google Scholar] [CrossRef] [PubMed]
- Liu, Y.; He, L.; Mustapha, A.; Li, H.; Hu, Z.Q.; Lin, M. Antibacterial activities of zinc oxide nanoparticles against Escherichia coli O157:H7. J. Appl. Microbiol. 2009, 104, 1193–1201. [Google Scholar] [CrossRef]
- Jo, Y.K.; Kim, B.H.; Jung, G. Antifungal Activity of Silver Ions and Nanoparticles on Phytopathogenic Fungi. Plant Dis. 2009, 93, 1037–1043. [Google Scholar] [CrossRef]
- Malandrakis, A.A.; Kavroulakis, N.; Chrysikopoulos, C.V. Zinc nanoparticles: Mode of action and efficacy against boscalid-resistant Alternaria alternata isolates. Sci. Total Environ. 2022, 829, 154638. [Google Scholar] [CrossRef]
- Bartnicki-Garcia, S. Cell wall chemistry, morphogenesis, and taxonomy of fungi. Annu. Rev. Microbiol. 1968, 22, 87–108. [Google Scholar] [CrossRef] [PubMed]
- Pal, S.; Tak, Y.K.; Song, J.M. Does the antibacterial activity of silver nanoparticles depend on the shape of the nanoparticle? A study of the Gram-negative bacterium Escherichia coli. Appl. Environ. Microbiol. 2007, 73, 1712–1720. [Google Scholar] [CrossRef] [PubMed]
- Yamanaka, M.; Hara, K.; Kudo, J. Bactericidal actions of a silver ion solution on Escherichia coli, studied by energy-filtering transmission electron microscopy and proteomic analysis. Appl. Environ. Microbiol. 2005, 71, 7589–7593. [Google Scholar] [CrossRef]
- Galeano, B.; Korff, E.; Nicholson, W.L. Inactivation of vegetative cells, but not spores, of Bacillus anthracis, B. cereus, and B. subtilis on stainless steel surfaces coated with an antimicrobial silver- and zinc-containing zeolite formulation. Appl. Environ. Microbiol. 2003, 69, 4329–4331. [Google Scholar] [CrossRef] [PubMed]
- Aguilar-Méndez, M.A.; San Martín-Martínez, E.; Ortega-Arroyo, L.; Cobian-Portillo, G.; Sanchez-Espindola, E. Synthesis and characterization of silver nanoparticles: Effect on phytopathogen Colletotrichum gloesporioides. J. Nanopart. Res. 2011, 13, 2525–2532. [Google Scholar] [CrossRef]
- Hwang, E.T.; Lee, J.H.; Chae, Y.J.; Kim, Y.S.; Kim, B.C.; Sang, B.I.; Gu, M.B. Analysis of the toxic mode of action of silver nanoparticles using stress-specific bioluminescent bacteria. Small 2008, 4, 746–750. [Google Scholar] [CrossRef] [PubMed]
- Kalia, A.; Abd-Elsalam, K.A.; Kuca, K. Zinc-Based Nanomaterials for Diagnosis and Management of Plant Diseases: Ecological Safety and Future Prospects. J. Fungi 2020, 6, 222. [Google Scholar] [CrossRef] [PubMed]
- Sahar, M.O. Antifungal Activity of Silver and Copper Nanoparticles on Two Plant Pathogens, Alternaria alternata and Botrytis cinerea. Res. J. Microbiol. 2014, 9, 34–42. Available online: https://scialert.net/abstract/?doi=jm.2014.34.42 (accessed on 9 October 2023).

| Microparticles | dwet | ddry |
|---|---|---|
| ALG/Zn | 681.06 ± 92.52 c | 381.54 ± 41.27 c |
| CS/(ALG/Zn) | 852.17 ± 47.35 b | 515.50 ± 1.93 b |
| ALG/(Zn+Ag) | 915.46 ± 23.88 b | 598.24 ± 6.85 a |
| CS/(ALG/(Zn+Ag)) | 1112.48 ± 33.81 a | 557.52 ± 2.03 ab |
| Microparticles | Ra/nm | Rq/nm | Z Range/nm |
|---|---|---|---|
| ALG/Zn | 76 ± 1 a | 106 ± 2 a | 1127 ± 21 a |
| CS/(ALG/Zn) | 7.47 ± 0.02 d | 9.20 ± 0.08 d | 53.09 ± 0.67 d |
| ALG/(Zn+Ag) | 21.97 ± 0.52 b | 28.88 ± 0.74 b | 248.33 ± 0.96 b |
| CS/(ALG/(Zn+Ag) | 18.62 ± 0.45 c | 23.19 ± 0.68 c | 181 ± 2 c |
| Microparticles | EEZn | EEAg | LCZn | LCAg | Sw |
|---|---|---|---|---|---|
| ALG/Zn | 87.21 ± 0.49 a | - | 14.19 ± 0.83 a | - | 15.43 ± 3.82 d |
| CS/(ALG/Zn) | 87.21 ± 0.49 a | - | 8.91 ± 0.11 b | - | 43.8 ± 1.65 b |
| ALG/(Zn+Ag) | 87.32 ± 0.40 a | 99.99 ± 0.001 a | 15.27 ± 0.83 a | 19.48 ± 0.50 a | 25.12 ± 0.11 c |
| CS/(ALG/(Zn+Ag)) | 87.32 ± 0.40 a | 99.99 ± 0.001 a | 7.71 ± 0.52 b | 4.22 ± 0.47 b | 66.33 ± 0.45 a |
| Microparticles | kZn | nZn | kAg | nAg |
|---|---|---|---|---|
| ALG/Zn | 0.51 | 0.02 | - | - |
| CS/(ALG/Zn) | 0.26 | 0.03 | - | - |
| ALG/(Zn+Ag) | 0.50 | 0.07 | 0.07 | 0.06 |
| CS/(ALG/(Zn+Ag)) | 0.31 | 0.06 | 0.02 | 0.07 |
| Control | Antifungal Test | |||
|---|---|---|---|---|
| 1 mL dH2O/10 mL PDA + B. cinerea | 1 mL CS/(ALG/(Zn+Ag)) /10 mL PDA + B. cinerea | 1 mL ALG/(Zn+Ag) /10 mL PDA + B. cinerea | 1 mL ALG/Zn /10 mL PDA + B. cinerea | |
| (cm2) ± SD | 57.5 ± 0.2 a | 41.7 ± 1.9 b | 10.1 ± 1.3 c | 37.2 ± 2.0 d |
| I (%) | 0% | 27.5% | 82.5% | 35.4% |
| Control | Antifungal Test | |||
|---|---|---|---|---|
| 2 mL dH2O/10 mL PDA B. cinerea | 2 mL CS/(ALG/(Zn+Ag)) /10 mL PDA + B. cinerea | 2 mL ALG/(Zn+Ag) /10 mL PDA + B. cinerea | 2 mL ALG/Zn /10 mL PDA + B. cinerea | |
| (cm2) ± SD | 56.2 ± 0.4 a | 13.6 ± 0.8 b | 0.6 ± 1.3 c | 4.3 ± 1.9 c |
| I (%) | 0% | 75.8% | 98.9% | 92.3% |
Disclaimer/Publisher’s Note: The statements, opinions and data contained in all publications are solely those of the individual author(s) and contributor(s) and not of MDPI and/or the editor(s). MDPI and/or the editor(s) disclaim responsibility for any injury to people or property resulting from any ideas, methods, instructions or products referred to in the content. |
© 2023 by the authors. Licensee MDPI, Basel, Switzerland. This article is an open access article distributed under the terms and conditions of the Creative Commons Attribution (CC BY) license (https://creativecommons.org/licenses/by/4.0/).
Share and Cite
Vinceković, M.; Jurić, S.; Vlahoviček-Kahlina, K.; Martinko, K.; Šegota, S.; Marijan, M.; Krčelić, A.; Svečnjak, L.; Majdak, M.; Nemet, I.; et al. Novel Zinc/Silver Ions-Loaded Alginate/Chitosan Microparticles Antifungal Activity against Botrytis cinerea. Polymers 2023, 15, 4359. https://doi.org/10.3390/polym15224359
Vinceković M, Jurić S, Vlahoviček-Kahlina K, Martinko K, Šegota S, Marijan M, Krčelić A, Svečnjak L, Majdak M, Nemet I, et al. Novel Zinc/Silver Ions-Loaded Alginate/Chitosan Microparticles Antifungal Activity against Botrytis cinerea. Polymers. 2023; 15(22):4359. https://doi.org/10.3390/polym15224359
Chicago/Turabian StyleVinceković, Marko, Slaven Jurić, Kristina Vlahoviček-Kahlina, Katarina Martinko, Suzana Šegota, Marijan Marijan, Ana Krčelić, Lidija Svečnjak, Mislav Majdak, Ivan Nemet, and et al. 2023. "Novel Zinc/Silver Ions-Loaded Alginate/Chitosan Microparticles Antifungal Activity against Botrytis cinerea" Polymers 15, no. 22: 4359. https://doi.org/10.3390/polym15224359
APA StyleVinceković, M., Jurić, S., Vlahoviček-Kahlina, K., Martinko, K., Šegota, S., Marijan, M., Krčelić, A., Svečnjak, L., Majdak, M., Nemet, I., Rončević, S., & Rezić, I. (2023). Novel Zinc/Silver Ions-Loaded Alginate/Chitosan Microparticles Antifungal Activity against Botrytis cinerea. Polymers, 15(22), 4359. https://doi.org/10.3390/polym15224359

